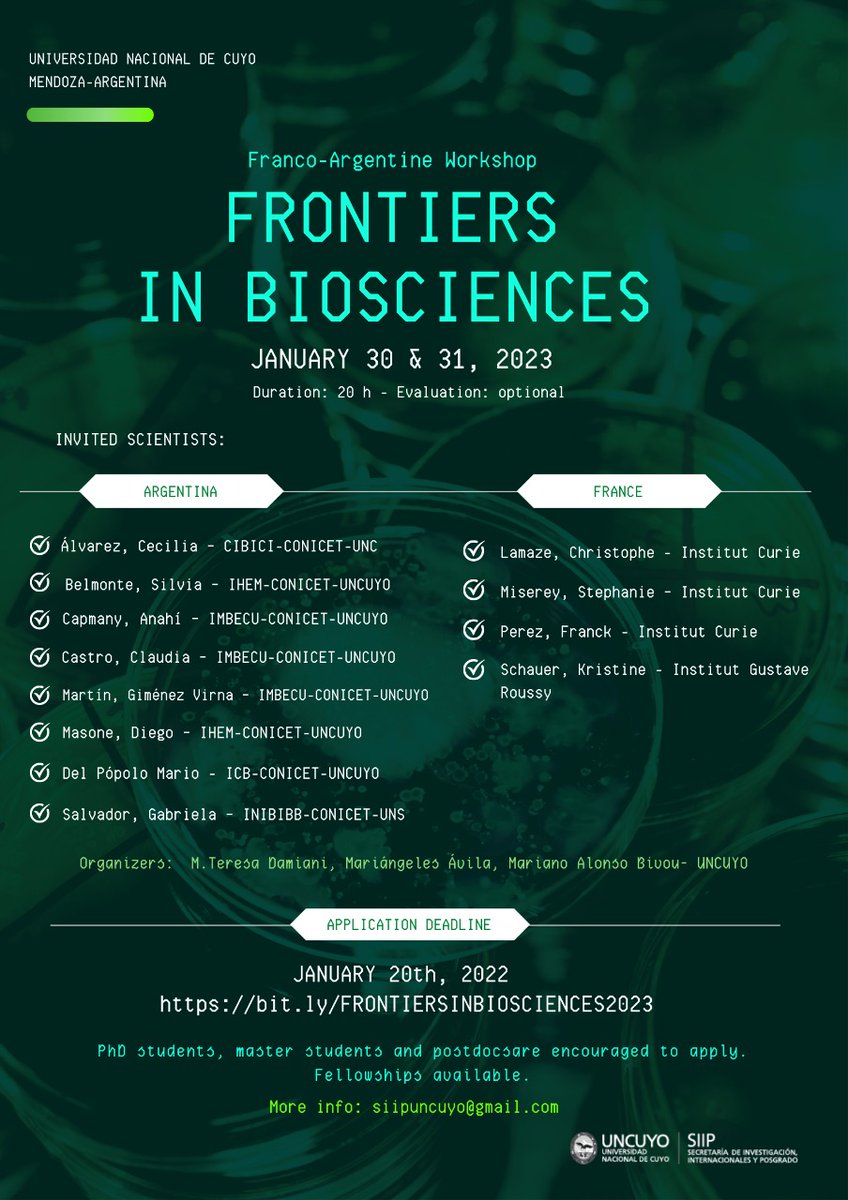
#uncuyo #workshop #mendoza
The course will be comprised of seminar sessions presented by very experienced and successful researchers from Paris, France, and different provinces of Argentina.

Mariano Alonso
@marianoaab
ID: 3042265773
17-02-2015 11:22:32
52 Tweet
39 Followers
429 Following






What are 26 different Rab GTPases doing on Lipid Droplets? Are lipids transferred by membrane contact sites? Moving the FAT: Emerging roles of Rab GTPases in the regulation of lipid droplet contact sites by Mariano Alonso @albertpol10 and Harriet P Lo sciencedirect.com/science/articl…




'The Evolution of Grandparents'. You may look for it on #Nature. #Evolution #Abuelito #iFDV bit.ly/qUNUQV via Mail Online







Individuals' blood glucose levels after meals may be predictable bit.ly/1OfQTRD [Podcast] By Cynthia Graber